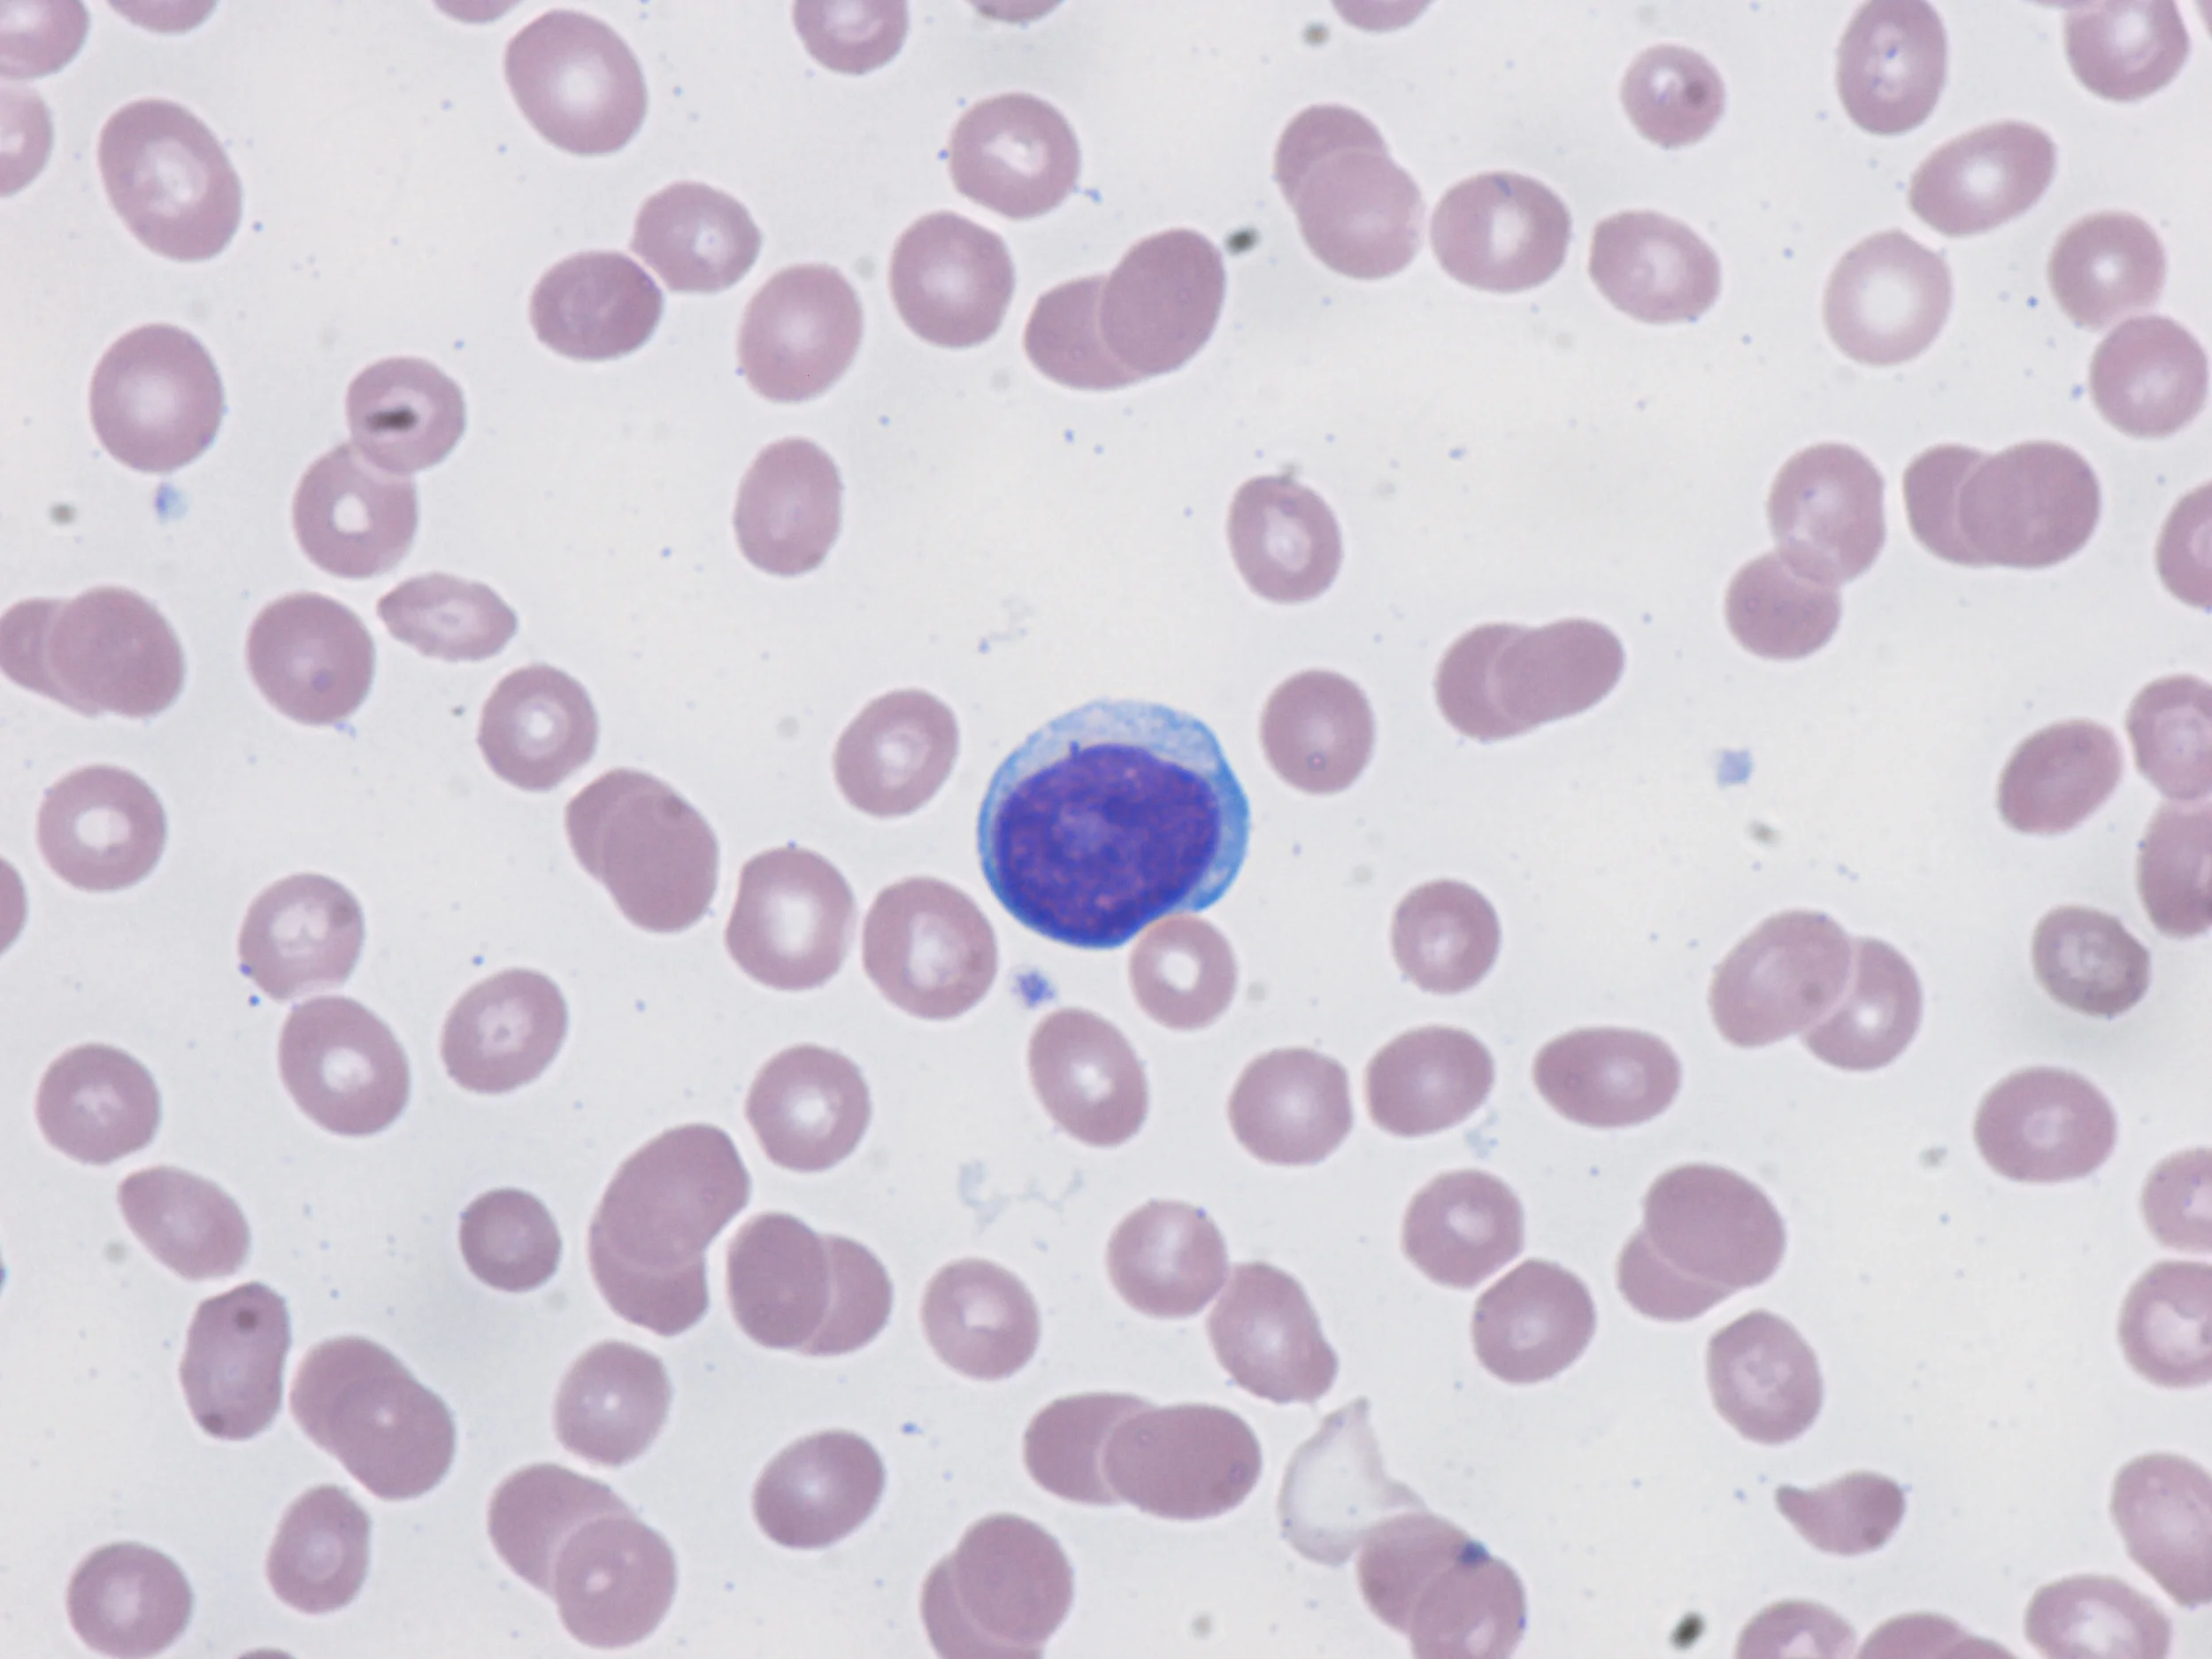

Mature Bläst

👉🏻👉🏻👉🏻 ALLE INFORMATIONEN HIER! KLICKE HIER 👈🏻👈🏻👈🏻
Blasen - Mature Album
Schlucken - Mature Album
Blasen - tief in die kehle, german blasen . . . - Mature Moms
Mature blowjob porn: 389,332 free sex videos @ pornSOS .com
Blasen - Granny Cinema Mature Tube
Blasen - 464,378 Videos - Grandmamma Movies - Free mature porn
Abspritzen - Mature Album
Abspritzen zusammenstellung - Mature Album
Saugen - saugen und schlucken, german mature saugen :: HQ . . .
Filipina - Mature Album
Strassen Pornos
Deutsche Teen Fickt
Deutsche Free Pornos
Erotikclips Free
Porno Mann Frau
www .maturealbum .com /de/106/blowjob/
Porno Videos: "Blasen" - 464,383 Videos . Blasen, Handarbeit, Blowjobs, Blasen Deutsch, Blasen Und Schlucken, Schlucken und vieles mehr .
www .maturealbum .com /de/924/swallow/
Porno Videos: "Schlucken" - 21,531 Videos . Schlucken, Schlucken Deutsch, Sperma Schlucken, Blasen, Transen, Sperma Im Mund und vieles mehr .
www .maturemoms .tv /de/blasen .html
Blasen: reif geil blasen schlucken, geile reife fotze 60, ehefrau schluckt, unerwartet spritzen, reif blasen, riesen ladung sperma im mund, glied Mature Moms TV Hauptseite Fap 18 Porn
Sexy mature wife gets naked, blows a cock and rubs her pussy 04:57 . sexy mature milf having a real orgasm with her photographer 06:30 . Mature suck swallow, homemade mature blowjob 06:14 . Male Pole O Neal - Intercourse In The Farm (2001) Special Edition - Double penetration 2 days ago 1:32:47 . Mature Amatuer Beef Eater 05:02 . Stacked amateur wife enjoys a hot ride of fucking POV style 14:52 . . .
www .grannycinema .com /de/106/blowjob/
Vor 3 Monaten 10:33 Deviants blasen; Hot blonde mature gives a great pov blowjob Vor 2 Jahren 06:52 HClips blasen; Slim matures share the dick in sunny outdoor fetish scenes Vor 1 Monat 04:58 HellPorno blasen, sperma im mund, oma, draussen, amateure; Mature suck off amateur 3 Vor 1 Monat 09:25 Sexu blasen, mutti, handarbeit, deutsch, stief
www .grandmammamovies .com /de/106/blowjob/
Blasen, Handarbeit, Blasen Und Schlucken, Kehlenfick, Deutsch Blasen, Dreier und vieles mehr .
www .maturealbum .com /de/944/cumshot/
Porno Videos: "Abspritzen" - 191,413 Videos . Abspritzen, Abspritzen Zusammenstellung, Handarbeit, Abspritzen Deutsch, Sperma Drinnen, Blasen und vieles mehr .
www .maturealbum .com /de/3399/cumshot_compilation/
Vor 3 Jahren 10:09 KatesTube abspritzen zusammenstellung, blasen, zusammenstellung, gesichtsbesamung Vor 9 Monaten 05:31 EmpFlix abspritzen zusammenstellung , voyeur , hausgemacht , amateure Heute 10:04 FetishShrine doppel penetration , russisch , sperma im mund , zusammenstellung , schlucken
www .hqtube .tv /de/1349/saugen .html
Saugen: german mature saugen, deutsch blasen und saugen, unerwartet spritzen, saugen und schlucken, blasen schlucken, happy video privat @ HQ Tube TV
www .maturealbum .com /de/2358/filipina/
Vor 5 Jahren 03:07 xHamster filipina, blasen, abspritzen; Vor 5 Jahren 04:37 NuVid filipina; Vor 1 Jahr 01:09 xHamster filipina, hausgemacht, sperma im mund; Vor 4 Jahren 11:47 TXXX filipina, magersüchtig; Vor 4 Jahren 02:32 xHamster filipina; Vor 6 Jahren 02:59 xHamster filipina; Vor 9 Monaten 24:35 xTits filipina, betrogen, asiatisch, realität; Vor 3 Jahren 29:05 TXXX filipina; Vor 1 Jahr . . .
Mom Fickt
Junges Paar Bei Ihrem Ersten Geilen Sonntagsfick
Apolonia Porn
Nicole Kidman Porno
Angel Allwood
Alles Cool Am Pool Die Susse Blast Ausgezeichnet - Pornhub Deutsch
Im Studentenheim Geht Heiß Her - Pornhub Deutsch
Frauen Machen Es Sich Selbst
Schon Versaut - Gangbang Mit Besamung - Pornhub Deutsch
Sex Im Mieder
Junges Swingerpaar - Pornhub Deutsch
Sex Im Auto Videos
Deutsche Omas - Pornos Deutsch
Die Orgasmus Therapie - Pornhub Deutsch
Anal Milf
Nubile Videos
Deutscher Dreier Porno
Schone Lesbische Teenies - Zierlich, Jung, Blond Und Brunett - Pornhub Deutsch
Schlampige Milf Im Freien Klar Gemacht Und Gefickt - Pornhub Deutsch
Eva Green Sexy
Nasse Muschi
Porno Masturbieren
Steck Ihn Rein Und Fick Mich Hart - Blonder Teensex Mit Einem Super Engen Babe - Pornhub Deutsch
Krankenhaus Pornos
Die Geilen Stripperinnen Beim Live Act - Pornhub Deutsch
Porno Milf Deutsch
Free Sex Clips
Ladyboy Porno
Willige Fotzen 2 - Pornhub Deutsch
Porno Mia Malkova
Geile Weibe
Laden Sie Einen Jungen Schuler Zu Hause Ein Und Holen Sie Sich Den Ganzen Schwanz Von Anfang An | Kostenlose Pornos Deutsch, Deutsch Porno Sexfilme Hd Und Gratis Pornofilme
Eine Schlanke Jung Gebliebene Grauhaarige Oma Beim Sex - Sie Bekommt Eine Gewaltige Spermaladung Ins Gesicht - Cougar Gilf - Pornhub Deutsch
Youporn.
Piss Fetisch
Mädchen Hot
Yaptube
Sie Fragt Ihn, Wenn Man Sieht, Wie Wenig Teufel War Up Dick | Kostenlose Pornos Deutsch, Deutsch Porno Sexfilme Hd Und Gratis Pornofilme
Junge Geile
Sexy Pussy
Hot Lesben
Fingern Frauen
Inzest Sex Story
Zeichentrik Porno
Der Putzmann - Pornhub Deutsch
Xxx Fotze
Dildo Hentai
Sex Mit Gemüse
Zoophilie Geschichten
Geile Nutte Ficken
Roxanna Und Katie - Zwei Naturliche Scharfe Girls Beim Fotzenlecken - Pornhub Deutsch
Private Votzen
Free Animal Porn Videos
Deutsche Oma Außer Rand Und Band - Pornhub Deutsch
Straps Porno
Richtig Geile Frauen
Mollige Milf Mit Großen Brusten - Solo Auf Einem Stuhl - Pornhub Deutsch
Enge Muschi Gefickt
Sarina Valentina
Sex Ist Besonders Geil, Wenn Von Jungem Amateurparchen Gemacht - Pornhub Deutsch
Amateur Fickspiele Im Hotel - Der Geile Sex Hinter Verschlossenen Hotelzimmerturen - Pornhub Deutsch
Www.Porno-De
Leder Porn
Packett - Pornos Deutsch
Afrika Titten
Xxx Bruder Und Schwester
Lolastube
Deutsche Fetisch Pornos - Pornos Deutsch
Sexvidio Omasex Kostenlos
Fundorado.Com
Vier Schwanze Ficken Ihren Mund Bis Sie Kommen - Pornhub Deutsch
Blondinen Porn
Blondes Nerd Madchen Will Anal Fick - Pornhub Deutsch
Paar Beim Ficken - Pornos Deutsch
Hamszer Porn
Kostenlos Sexvideos
Gepoppt - Pornos Deutsch
Vater Fickt Kostenlos Seine 18 Jahrige Tochter - Deutsche Pornos Kostenlos
Www Anal Sex Com
Iris Mareike Steen Sexy
Beathe Uhse.De
Casting Fuck
Gxnxx
Neue Teen Pornos
Spy Porn Tube
Briana Lee - Luder Bearbeitet Amateurin Mit Vibrator - Pornhub Deutsch
Nackte Teenys
Er Hat Einen Geilen Schwanz Fur Diese Englische Blonde Mutter - Eine Blonde Amateur Milf Aus England In Strapse Gefickt - Pornhub Deutsch
Deutsche Chefin - Pornos Deutsch
Daisy Lynne
Gaile Titten
Fahrrad Sex
Grannysex
Alarm Feuerwehr Porno
Massagetisch
Vati Hat Mich Richtig Hart Rangenommen (Teen Hardcorefilm) - Pornhub Deutsch
Maschinen Porno
Besamung Zweier Heisser Asia Teens In Fishnets - Doppeler Creampie - Pornhub Deutsch
Blasen Deutsch
Gepiercte Teenagerin Reitet Harten Schwanz - Junges Luder - Pornhub Deutsch
Mature Bläst































































![]()



/red_blood_cells_1-57b20c583df78cd39c2f8e15.jpg)